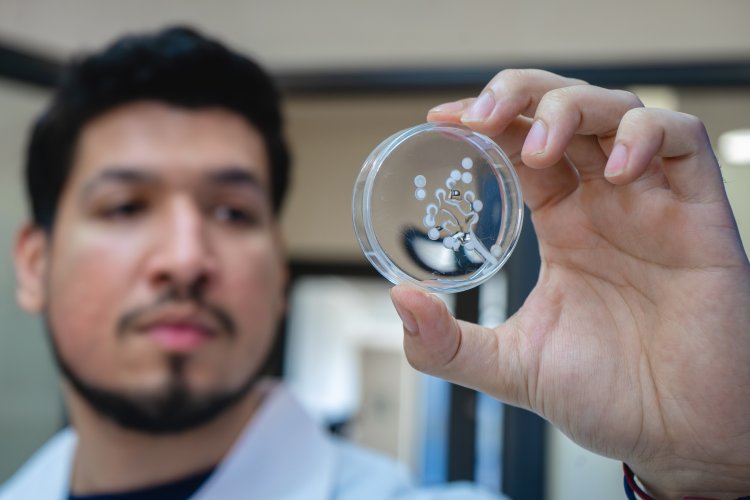
Investigadores crean hidrogel a base de veneno de avispa que cura lesiones de pie diabético

Investigadores crean hidrogel a base de veneno de avispa que cura lesiones de pie diabético
Péptido derivado de la toxina de avispa trata las infecciones de este tipo de heridas. Este mismo mecanismo podría dar nueva vida a antibióticos obsoletos
Fuente: Comunicaciones UTalca. Autor: septimapaginanoticias.cl
Un equipo de investigación de la Universidad de Talca desarrolló un hidrogel innovador capaz de combatir infecciones causadas por bacterias multirresistentes, como Staphylococcus aureus y Pseudomonas aeruginosa.
El avance se basa en un péptido derivado de la toxina de avispa, que permite tratar heridas de pie diabético con una eficacia superior a los métodos convencionales.
Este descubrimiento es parte del trabajo que ejecuta el profesor Esteban Durán Lara del Departamento de Microbiología de la Universidad de Talca, quien lidera la iniciativa y que, desde hace más de 5 años, estudia nanopartículas e hidrogeles para tratar infecciones y combatir la resistencia a los antibióticos tradicionales.
El científico destacó este hallazgo, en el que obtuvieron resultados concretos y que permite mejorar las infecciones en heridas de pie diabético.
“Generamos un hidrogel al que agregamos un compuesto péptido. Podemos incorporar cualquier droga, en este caso usamos un derivado de la toxina de una avispa que tiene acción contra bacterias resistentes a los antibióticos comerciales, como el Staphylococcus aureus, Acinetobacter baumannii o Pseudomona aeruginosa”, explicó.
Lo interesante del hidrogel es que libera lentamente el péptido. “Se degrada rápidamente perdiendo su efecto antimicrobiano”, planteó el investigador de la Facultad de Ciencias de la Salud. Adicionalmente, la formulación desarrollada puede ser aplicada como un líquido que gelifica cuando entra en contacto con la herida.
Durán agregó que en el laboratorio “comprobamos que, tras la aplicación, cerca del día 8 la herida comienza a mejorar notablemente para sanar totalmente al día 16”.
Otro beneficio en este tratamiento es que el hidrogel sólo se coloca una vez, a diferencia de otros sistemas convencionales, los que deben aplicarse todos los días a la herida.
La investigación es parte del proyecto Fondecyt que realiza el académico denominado “Síntesis de nuevos hidrogeles polianiónicos con respuesta dual para la eliminación de pépticos antimicrobianos helicoidales en infecciones asociadas a bacterias multi-resistentes”, financiado por ANID.
Ahora los investigadores deberán comprobar cómo este mismo péptido puede recuperar antibióticos obsoletos y darles una nueva vida, a través de efectos sinérgicos que potencian la acción del antibiótico convencional.
“Tenemos algunos resultados -señaló el profesor Durán- que demuestran que este péptido potencia la eficacia de los antibióticos convencionales. La idea es incorporarlo en un hidrogel para que actúe de manera sinérgica, permitiendo recuperar estos antibióticos como un producto de aplicación dérmica”.
Adicionalmente, el académico, explicó que, “también estamos viendo la posibilidad de administrarlos por otras vías, como la gástrica para infecciones internas más complejas”.
El producto actualmente se está desarrollando y avanzando en sus procesos científicos, en laboratorio, por lo que no llegará al mercado en el corto plazo.
El científico precisó que, en Chile, aunque es posible patentar innovaciones como ésta, la adjudicación de proyectos de investigación se basa en gran medida en la publicación de resultados en revistas científicas de alto impacto. “Su mayor valor académico radica en la generación de conocimiento y su difusión a través de publicaciones especializadas”, sostuvo.
“Nos gustaría poder utilizar este material. Si bien los permisos sanitarios implican procesos administrativos exigentes, hemos explorado distintas alternativas para su aplicación”, indicó.
Asimismo, agregó que, “existe la posibilidad de desarrollarlo en el ámbito veterinario y de establecer colaboraciones directas con la industria farmacéutica”.
CIFRAS:
- 8 días demoran las heridas en comenzar a sanar con el hidrogel creado en la UTalca.
- 16 días se demora este producto en sanar completamente la lesión.
- 1 es la cantidad de veces en que se debe aplicar el hidrogel en el pie diabético.
- 32: son los antibióticos en fase de desarrollo clínico que -según la OMS- son capaces de combatir una lista de patógenos prioritarios.

















